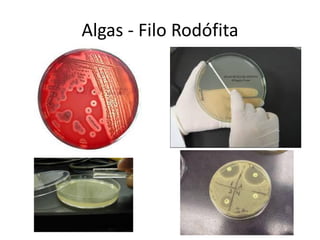
Algas - Filo Rodófita

O documento descreve a evolução das plantas, desde as primeiras algas na água há 500 milhões de anos até as angiospermas modernas. Detalha a classificação dos vegetais em algas, briófitas, pteridófitas, gimnospermas e angiospermas, e como cada grupo conquistou novos ambientes e características ao longo do tempo.